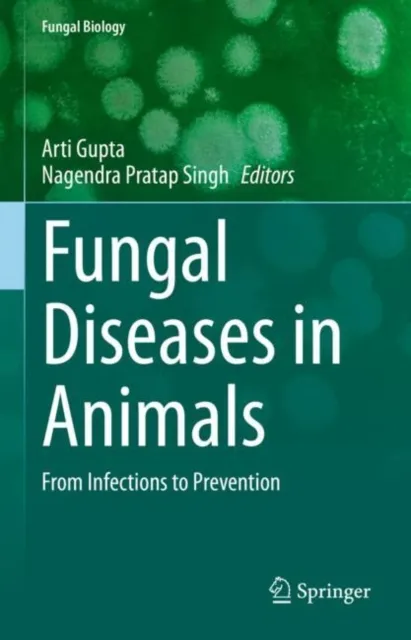
Fungal Diseases in Animals

£99.50
Role of Birds in Transmitting Zoonotic Pathogens

Introduction
Zoonotic diseases pose a serious threat to global health and economy. Domestic and wild birds play crucial roles in transmission and spread of important zoonotic pathogens, with significant implications on human and avian health. Although zoonotic diseases have been extensively studied, information on various aspects of avian zoonotic pathogens have not been revisited or revised to any great extent. This book is a comprehensive and updated compilation of important zoonotic diseases that are transmitted by domestic and wild birds, and consists of 21 chapters that meticulously describe the (i) etiology and evolution, (ii) complex epidemiology, such as migration pathways in context of disease transmission, (iii) pathogenesis, (iv) clinical signs and necropsy findings, (v) diagnostics including latest molecular assays, and (vi) preventative and control strategies, with an emphasis on therapeutics and prophylaxis, of important zoonotic pathogens (bacterial, fungal, parasitic and viral) of avian origin in humans and birds. Each chapter is aptly supported by interactive tables and figures, and features an updated reference section. This book aims to create awareness and enlighten students of veterinary and human medicine on the role of birds in zoonoses, and would serve as a useful reference for working veterinarians, human doctors, and public health experts.